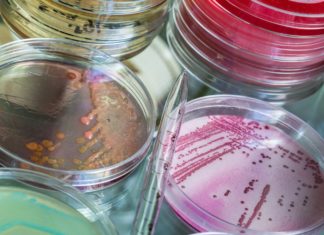
Найден новый способ синтезирования антибиотиков

Eriba создала уникальный жилой трейлер
Вполне возможно, что компании Eriba удалось создать наиболее идеальный концепт семейного трейлера, который был продемонстрирован пользователям во время проведения автомобильной выставки CMT в...
LG работает над собственными ИИ-чипами
Несмотря на то, что компания LG все еще продолжает испытывать немало проблем относительно постоянных поставок и улучшений своей мобильной продукции, она вовсе не...
Специалисты из Корнуолла готовят новый тип QR-пакетов для молока
Пищевая промышленность на данный момент переживает самый настоящий пик технологической революции, которая выражается в самом широком комплексе аспектов – начиная от производства еды...
Предложен новый тип контрацептивов
Контрацептивы редко являются удобными – некоторые из них, будучи инвазивными, нередко вызывают неприятные побочные эффекты, а другие просто оказываются бесполезными при иных обстоятельствах....
ASUS ZenFone 6 обзаведется уникальной камерой
В современном мире мобильной индустрии присутствует довольно много интересных и в то же время странных моментов – и технический дизайн камер также можно...
Компания OnePlus внезапно выпустила беспроводные наушники Bullets Wireless 2
Судя по всему в этом году компания OnePlus планирует нас постоянно удивлять, ведь вчера она официально представила новые беспроводные наушники, которые имеют название Bullets...
Судя по всему версия Photoshop CC для iPad уже близка к...
Программа Photoshop заслуженно считается одним из самых гибких и универсальных редакторов изображений. С каждым годом всё больше и больше людей приобщаются к данному редактору....
Япония создаёт новый сверхскоростной поезд Alfa-X
Японский поезд-пуля нового поколения под названием Alfa-X успешно прошёл первые испытания. Поезд, строительством которого будут заниматься компании Kawasaki Heavy Industries и Hitachi, сможет развивать...
Компания DJI подготавливает новую экшн-камеру OSMO
Какое-то время тому назад компания GoPro считалась самым настоящим монополистом в сегменте портативных экшн-камер – однако теперь, с появлением новых технических концептов и...
Найден новый способ синтезирования антибиотиков
Эволюция – действительно невероятный и увлекательный в наблюдении процесс, который так или иначе все чаще поддается с течением времени новым научным изысканиям и...